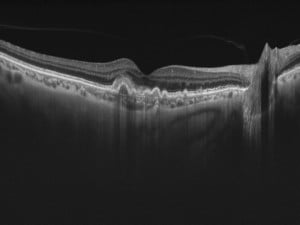

Categorie
Articoli recenti
- I BISOGNI (REALI) DEL PAZIENTE OFTALMOLOGICO
- DIGITAL HEALTH E SETTORE OFTA: COSA PREVEDE IL PIANO NAZIONALE DI RIPRESA E RESILIENZA?
- LA TELEOFTALMOLOGIA APPLICATA CON SUCCESSO A GENOVA
- TESTALAVISTA: UPVALUE E COMITATO MACULA INSIEME PER LA PREVENZIONE DI RD E EMD
- ONLINE E WIRELESS: LA TECNOLOGIA DIGITALE AL SERVIZIO DEL PAZIENTE OFTALMOLOGICO